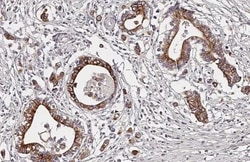
Invitrogen D4 Dopamine Receptor Recombinant Rabbit Monoclonal Antibody

missing translation for 'onlineSavingsMsg'
Learn More
Learn More
Invitrogen™ D4 Dopamine Receptor Recombinant Rabbit Monoclonal Antibody (HL2850)


Rabbit Recombinant Monoclonal Antibody
Brand: Invitrogen™ MA556684
This item is not returnable.
View return policy
Description
D4 Dopamine Receptor Recombinant Monoclonal Antibody for Western Blot, IHC (P)
This gene encodes the D4 subtype of the dopamine receptor. The D4 subtype is a G-protein coupled receptor which inhibits adenylyl cyclase. It is a target for drugs which treat schizophrenia and Parkinson disease. Mutations in this gene have been associated with various behavioral phenotypes, including autonomic nervous system dysfunction, attention deficit/hyperactivity disorder, and the personality trait of novelty seeking. This gene contains a polymorphic number (2-10 copies) of tandem 48 nt repeats; the sequence shown contains four repeats.
Specifications
| D4 Dopamine Receptor | |
| Recombinant Monoclonal | |
| 1 mg/mL | |
| PBS with no preservative | |
| P21917 | |
| DRD4 | |
| Synthetic peptide encompassing a sequence within the Extracellular domain human of Dopamine Receptor D4. The exact sequence is proprietary. | |
| 100 μL | |
| Primary | |
| Human | |
| Antibody | |
| IgG |
| Immunohistochemistry (Paraffin), Western Blot | |
| HL2850 | |
| Unconjugated | |
| DRD4 | |
| AW125663; D(2C) dopamine receptor; D(4) dopamine receptor; D4DR; D4R; D4RA; Dopamine 4 receptor; Dopamine D4 receptor; dopamine receptor 4; dopamine receptor D4; DRD4; Drd-4; seven transmembrane helix receptor | |
| Rabbit | |
| Protein A | |
| RUO | |
| 1815 | |
| -20°C, Avoid Freeze/Thaw Cycles | |
| Liquid |
Product Content Correction
Your input is important to us. Please complete this form to provide feedback related to the content on this product.
Product Title
Spot an opportunity for improvement?Share a Content Correction